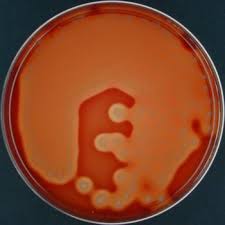

Kultur bakteri anaerob adalah metode yang digunakan untuk menumbuhkan spesimen klinis secara anaerob . Bakteri anaerob Obligat hanya bisa hidup tanpa adanya oksigen, anaerob obligat akan hancur saat kontak dengan atmosfer selama 10 menit. Beberapa anaerob ada yang toleran terhadap sejumlah kecil oksigen. Anaerob fakultatif adalah organisme yang dapat tumbuh dengan atau tanpa oksigen. Metode mendapatkan spesimen untuk kultur anaerobik dan prosedur biakan anaerob harus dilakukan untuk memastikan bahwa organisme terlindung dari oksigen.
Tujuan
Biakan bakteri anaerobik dilakukan untuk mengidentifikasi bakteri yang dapat menyebabkan infeksi pada manusia yang tumbuh hanya dalam ketiadaan oksigen . Infeksi bakteri anaerob dapat menyebabkan konsekuensi serius seperti amputasi , kegagalan organ, sepsis, meningitis, dan kematian. Biakan diperlukan untuk mengidentifikasi patogen anaerobik dengan benar dan pemilihan antibiotik yang efektif.
Tindakan pencegahan
Sangat penting bahwa penyedia layanan kesehatan untuk mendapatkan sampel klinis untuk dibiakkan melalui teknik aseptik . Bakteri anaerob umumnya ditemukan pada selaput lendir dan situs lainnya seperti vagina dan rongga mulut. Oleh karena itu, spesimen yang mungkin terkontaminasi dengan organisme ini tidak dianjurkan untuk dibiakkan (misalnya, vagina atau usap tenggorokan). Beberapa jenis spesimen harus selalu dibiakkan secara anaerob jika dicurigai ada infeksi . Ini termasuk abses, gigitan, darah, cairan tulang punggung / cairan otak dan cairan tubuh exudative, luka dalam, dan jaringan mati. Spesimen harus dilindungi dari oksigen selama pengumpulan dan transportasi kemudian harus dibawa ke laboratorium segera.
Deskripsi
Anaerob biasanya ditemukan di area tubuh tertentu , tetapi dapat mengakibatkan infeksi serius ketika mereka memiliki akses ke cairan tubuh yang biasanya steril atau ke jaringan dalam yang kurang oksigen. Beberapa anaerob biasanya tinggal di celah-celah kulit, di hidung, mulut, tenggorokan, usus, dan vagina. Cedera pada jaringan tersebut (yaitu, luka, luka tusuk, atau trauma) terutama pada atau berdekatan dengan membran mukosa memungkinkan bakteri anaerob masuk ke daerah tubuh yang steril tersebut dan menjadi penyebab utama infeksi bakteri anaerob. Sumber kedua infeksi anaerob terjadi akibat terpaparnya bagian tubuh yang secara normal steril dengan spora bakteri. Bakteri anaerob tinggal di tanah dan air, memproduksi spora, Spora tersebut dapat masuk melalui luka, terutama tusukan. Infeksi Anaerobik paling sering ditemukan pada orang yang imunosupresif, pada mereka yang baru dirawat dengan antibiotik spektrum luas, dan pada orang-orang yang memiliki cedera jaringan membusuk pada atau dekat membran lendir, terutama pada situs yang berbau busuk.
Beberapa spesimen yang patut dibiakkan secara anaerob adalah:
darah
empedu
sumsum tulang
cairan serebrospinal
aspirasi langsung paru-paru
biopsi jaringan dari suatu situs yang biasanya steril
cairan dari situs yang biasanya steril
abses gigi
abses abdominal atau panggul
luka pisau, tembak, atau bedah
terbakar yang parah
Beberapa spesimen yang tidak cocok untuk biakan anaerob meliputi:
discharge tenggorokan , batuk (dahak)
usap dubur
usap hidung atau tenggorokan
usap uretra
urin yang keluar lewat urethra
Koleksi Spesimen
Kunci efektif membiakkan bakteri anaerob termasuk mengumpulkan spesimen bebas kontaminasi dan melindunginya dari paparan oksigen atau. biakan bakteri anaerob harus diperoleh dari sebuah situs yang tepat tanpa terkontaminasi sampel yang berdekatan dengan bakteri dari kulit lendir, membran, jaringan. Kapas harus dihindari ketika mengambil spesimen untuk kultur anaerob karena serat kapas dapat merugikan anaerob. Abses atau cairan bisa disedot dengan menggunakan jarum steril yang kemudian ditutup rapat untuk mencegah masuknya udara. Sampel jaringan harus ditempatkan ke dalam kantong "degassed" dan disegel, atau dimasukkan botol bertutup ulir dan divacuum atas dimasukkan ke dalam botol berisi medium kultur prereduced bebas -oksigen dan ditutup rapat. Spesimen harus dipindah secepat mungkin ke media kultur yang telah disiapkan.
Kultur/biakan
Biakan harus ditempatkan dalam suatu lingkungan yang bebas oksigen, pada 95 ° F (35 ° C) setidaknya selama 48 jam sebelum diperiksa pertumbuhannya..
Pewarnaan Gram dilakukan pada spesimen pada saat dibiakkan. Infeksi dapat disebabkan oleh bakteri aerobik atau anaerobik atau campuran keduanya, beberapa infeksi memiliki probabilitas tinggi disebabkan oleh bakteri anaerob. Infeksi ini termasuk abses otak, abses paru-paru, aspirasi pneumonia , dan infeksi gigi. Organisme anaerobik sering dapat diduga karena banyak anaerob memiliki morfologi mikroskopis yang karakteristik . Sebagai contoh, Bacteroides spp. adalah batang gram-negatif yang pleomorphic (variabel dalam ukuran dan bentuk) dan menunjukkan pewarnaan bipolar yang tidak teratur Fusobacterium spp.. sering pucat berbentuk batang gram-negatif memiliki spindle . Clostridium spp.. adalah batang besar gram positif yang membentuk spora. Lokasi spora (pusat, subterminal, terminal, atau tidak ada) adalah karakteristik diferensial yang berguna. Adanya pertumbuhan, toleransi oksigen, dan hasil Gram stain cukup untuk menetapkan diagnosis awal infeksi anaerob dan memulai perawatan dengan obat antibiotik yang sesuai untuk sebagian besar anaerob seperti klindamisin, metronidazol, atau vankomisin.
Gram-negatif anaerob dan beberapa infeksi yang mereka hasilkan meliputi genera berikut:
Bacteroides (anaerob yang biasa ditemukan dalam biakan pada infeksi intra-abdomen, abses rektal, infeksi jaringan lunak, infeksi hati)
Fusobacterium (abses, infeksi luka, dan infeksi paru intrakranial)
Porphyromonas (aspirasi pneumonia , periodontitis)
Prevotella (infeksi intra-abdomen, infeksi jaringan lunak)
Gram-positif anaerob adalah sebagai berikut:
Actinomyces (kepala, leher, infeksi perut; aspirasi pneumonia )
Bifidobacterium (infeksi telinga, infeksi perut)
Clostridium (gas, gangren, keracunan makanan, tetanus, kolitis pseudomembranosa)
Peptostreptococcus (oral, pernapasan, dan infeksi intra-abdomen)
Propionibacterium (infeksi shunt)
Identifikasi anaerob sangat kompleks, dan laboratorium mungkin menggunakan sistem identifikasi parsial yang berbeda. tujuan. Misalnya, ada enam spesies dari genus Bacteroides yang dapat diidentifikasi sebagai kelompok Bacteroides fragilis daripada diidentifikasi secara individual. Organisme diidentifikasi berdasar kolonial dan morfologi mikroskopis mereka , pertumbuhan pada media selektif, toleransi oksigen, dan karakteristik biokimia. Ini termasuk fermentasi gula, kelarutan empedu, esculin, pati, dan hidrolisis gelatin, kasein dan lysis gel, katalase, lipase, lecithinase, dan produksi indol, reduksi nitrat, asam lemak volatil yang ditentukan dengan kromatografi gas, dan kerentanan terhadap antibiotik. Profil kerentanan antibiotik ditentukan oleh microtube metode dilusi . Banyak spesies anaerob yang resisten terhadap penisilin, dan ada pula yang tahan terhadap klindamisin dan antibiotik lain yang biasa. digunakan
Diagnosis / Persiapan
Penyedia perawatan kesehatan harus berhati-hati untuk mengumpulkan spesimen-bebas kontaminasi. Semua prosedur harus dilakukan secara aseptik. Perawat profesional kesehatan yang mengumpulkan spesimen harus siap untuk mengambil dua sampel, satu untuk biakan anaerob dan satu untuk biakan aerobik, karena tidak diketahui apakah patogen dapat tumbuh dengan atau tanpa oksigen. Selain itu, perawat kesehatan profesional harus mencatat antibiotik yang diberikan ke pasien saat pengambilan sampel dan kondisi medis lain yang dapat mempengaruhi pertumbuhan bakteri.
Rehabilitasi
Dalam sampling darah vena untuk biakan darah anaerob, langsung tekan harus diterapkan ke situs tusukan vena selama beberapa menit atau sampai pendarahan berhenti. Sebuah perban perekat dapat diterapkan, . Jika terjadi bengkak atau memar es dapat diterapkan ke situs. Untuk koleksi spesimen selain darah, pasien dan situs koleksi harus dipantau untuk setiap komplikasi setelah prosedur.
Risiko
Perhatian khusus harus dilakukan oleh tim kesehatan, mendapatkan, mengangkut, dan mempersiapkan spesimen untuk kultur anaerobik. metodologi yang buruk mungkin memperlamban identifikasi bakteri, menyebabkan kondisi pasien memburuk, dan mungkin memerlukan pasien untuk memberikan sampel lebih daripada yang akan diperlukan. Pasien mungkin mengalami memar, ketidaknyamanan, atau bengkak di situs koleksi ketika jaringan, darah, atau cairan lainnya diperoleh.
Hasil
Hasil negatif akan menunjukkan tidak ada pertumbuhan patogen dalam sampel. Hasil positif akan menunjukkan pertumbuhan, identifikasi setiap bakteri, dan uji kepekaan antibiotik
Pendidikan Pasien
Seorang anggota tim perawat kesehatan harus menjelaskan prosedur koleksi spesimen untuk pasien. Jika pasien sakit parah, anggota tim harus menjelaskan prosedur kepada anggota keluarga pasien. Pasien dan atau keluarganya dia harus memahami bahwa karena bakteri membutuhkan waktu untuk tumbuh di laboratorium, mungkin diperlukan beberapa hari untuk identifikasi bakteri.
PHOTO :
Bacteroides
Fusobacterium
Porphyromonas
Prevotella
Actinomyces
Bifidobacterium
Clostridium
C.botulinum


Clostridium tetani Clostridium difficile
 C. perfringens
C. perfringensPeptostreptococcus
Propionibacterium
Sumber Daya
BUKU
Anel, Ramon L. and R. Phillip Dellinger. "Sepsis and Bacteremia." In Conn's Current Therapy 2001, edited by Robert E. Rakel and Edward T. Bope. Philadelphia: W.B. Saunders Company, 2001, pp.56–62.
Fischbach, Frances. "Blood Cultures." In A Manual of Laboratory & Diagnostic Tests. 6th ed. Philadelphia: Lippincott Williams & Wilkins, 2000, pp.542–545.
Henry, J.B. Clinical Diagnosis and Management by Laboratory Methods. 20th ed. New York: W.B.Saunders Company, 2001.
Wallach, Jacques. Interpretation of Diagnostic Tests. 7th ed. Philadelphia, PA: Lippincott Williams & Wilkens, 2000.

Tidak ada komentar:
Posting Komentar